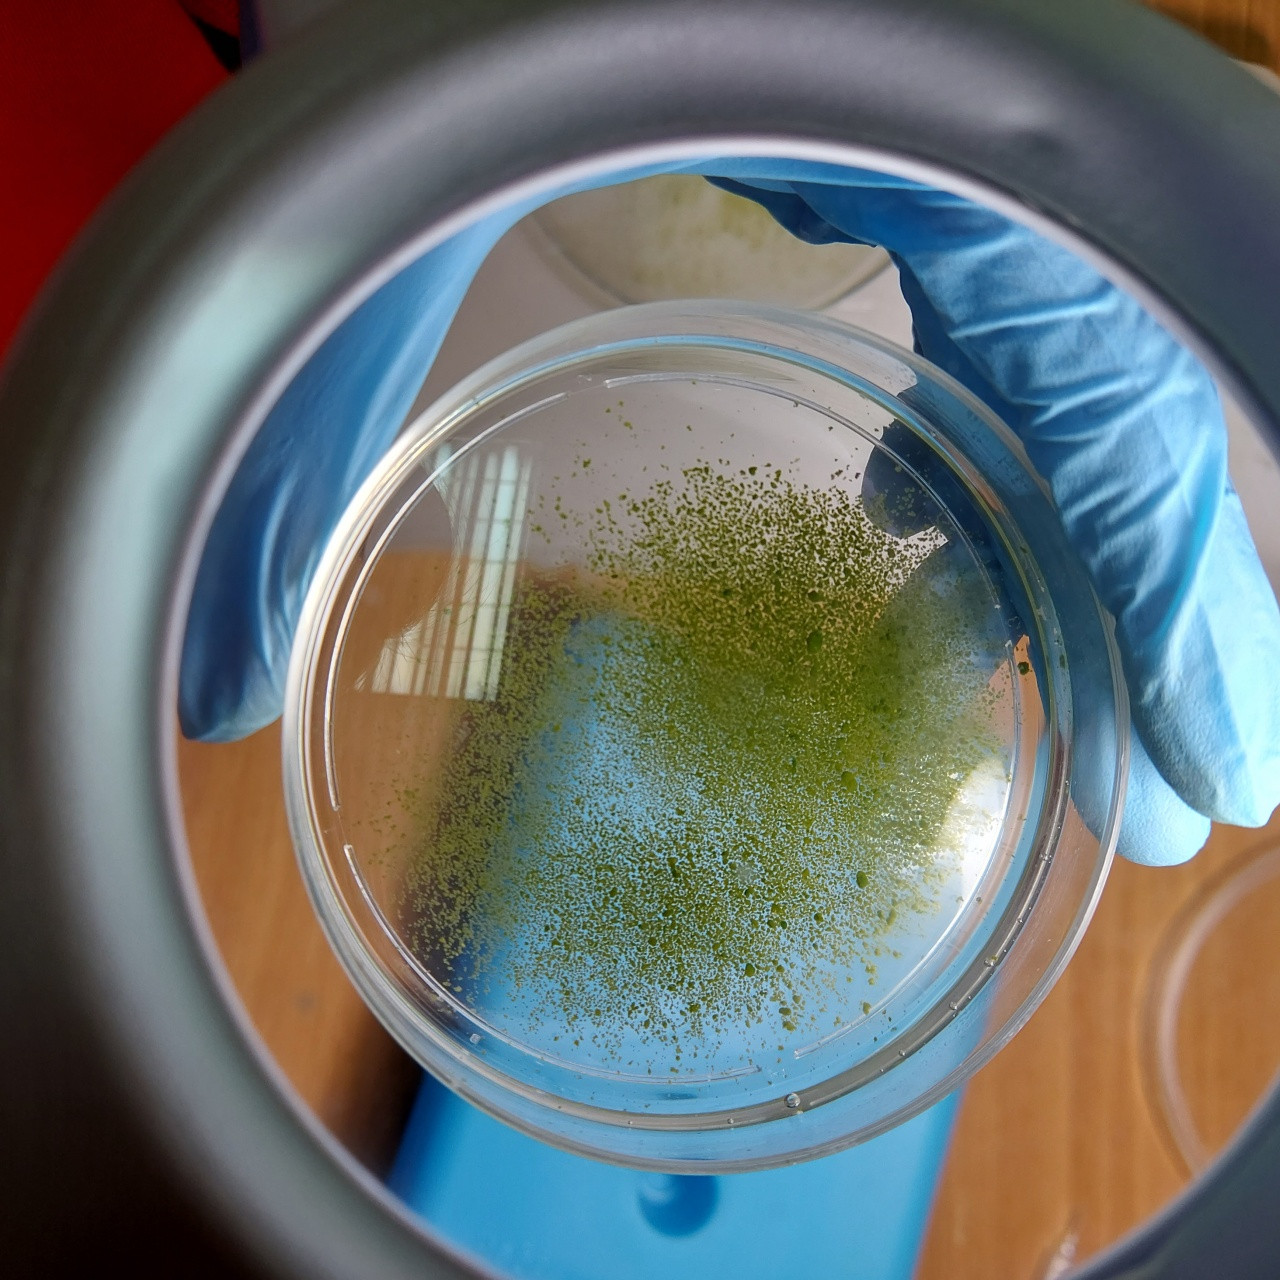
10

Expedition to collect sponges near the Bolshiye Koty settlement from 9 to 12 March 2021
The expedition to collect sponge samples was carried out near the Bolshiye Koty settlement from 9 to 12 March 2021 with the subsequent analysis of the composition of microorganisms in diseased and healthy specimens. The study area was the littoral zone between Skriper Cape and the Varnachka River at depths from 5 to 20 m.
The aim of the expedition was to study the causes of sponge disease using sponge cell culture as a model system.
Results of the expedition: 12 samples of conditionally healthy sponges, Lubomirskia baicalensis, without tissue damage visible under the water and 5 diseased members of this species, as well as 5 samples of the Baikalospongia bacillifera, were collected. Analysis of the outer cover revealed that both specimens of L. baicalensis had no visible disturbances. One of the B. bacillifera samples had a softened skeleton that easily disintegrated during transportation. Sponge samples were prepared for microscopic studies and DNA extraction. The main stages of obtaining primmorphs from healthy sponges were carried out.